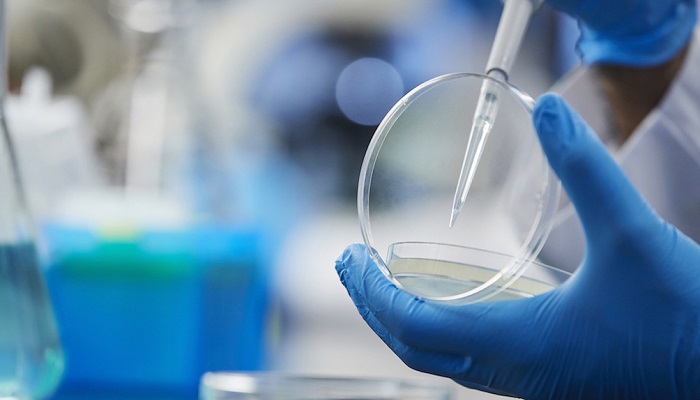

Close
Copyright © 2010-2026 World Pharma Today. All rights reserved. Publication of Leo Marcom Pvt Ltd.
We use cookies to improve your experience on our site. By using our site, you consent to cookies.
Websites store cookies to enhance functionality and personalise your experience. You can manage your preferences, but blocking some cookies may impact site performance and services.
Essential cookies enable basic functions and are necessary for the proper function of the website.
You can find more information in our Cookie Policy and Privacy Policy.